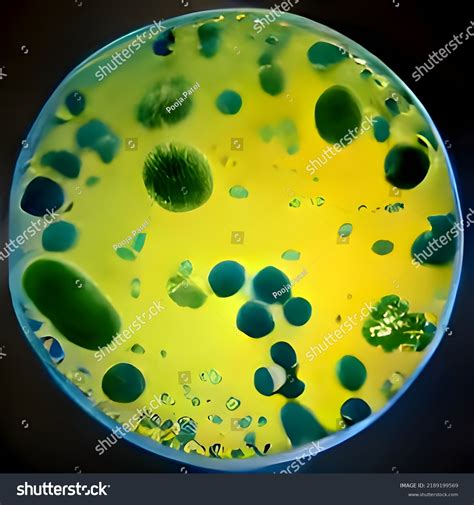
Stabligės bakterija mikroskopu

Stabligė - tai ūminė, dažnai mirtina infekcinė liga, kurią sukelia bakterijos Clostridium tetani išskiriamas toksinas. Šis toksinas pažeidžia nervų sistemą ir sukelia pavojingus raumenų spazmus. Nors stabligė nėra perduodama nuo žmogaus žmogui, ji kelia realų pavojų, ypač susižeidus. NVSC specialistai primena, kad rizika susirgti šia pavojinga infekcija yra didesnė, jei nuo paskutinių skiepų praėjo daugiau nei 10 metų.
Lietuvoje kasmet vidutiniškai užregistruojami 1-2 stabligės atvejai. NVSC duomenimis, 2010-2023 m. registruoti 22 stabligės atvejai, iš kurių 8 baigėsi mirtimi. Pernai šalyje ši liga buvo diagnozuota trims asmenims: vienam asmeniui, priklausančiam 18-24 m. amžiaus grupei, ir dviem - 25-44 m. amžiaus. Visi susirgusieji gydėsi ligoninėse. Šiemet sausio-liepos mėnesį buvo užfiksuotas vienas stabligės atvejis, deja, susirgęs asmuo neišgyveno.
Stabligės sporos aptinkamos daugelio žinduolių (arklių, avių, galvijų, šunų, kačių, žiurkių ir kt.) bei žmonių žarnyne. Su išmatomis jos patenka į dirvožemį. Nors stabligės sukėlėjas, patekęs į žmogaus organizmą per burną, ligos nesukelia, tačiau pakliuvus į žaizdas - užsikrečiama šia mirtina infekcija.

Skiepai - vienintelė apsauga
Stabligė dažniausiai serga vyresnio amžiaus asmenys. Vaikai pagal Lietuvos Respublikos vaikų profilaktinių skiepijimų kalendorių skiepijami vakcina, kuri apsaugo nuo stabligės, kokliušo ir difterijos. Šie skiepai atliekami sulaukus 2 mėn., 4 mėn., 6 mėn., 18 mėn., 6-7 m. ir 15-16 m. amžiaus. Kad būtų išlaikyta patikima ilgalaikė apsauga nuo šios infekcijos, suaugusiems skiepus rekomenduojama kartoti kas 5-10 metų, atsižvelgiant į skiepų aprašą. Lietuvoje 26 metų ir vyresni asmenys kas dešimtmetį skiepijami nemokamai. Suaugusiųjų skiepijimui naudojama vakcina apsaugo ne tik nuo stabligės, bet ir nuo difterijos. Svarbu pabrėžti, kad persirgus stablige ir pasveikus apsauginis imunitetas nesusiformuoja, todėl skiepai yra vienintelė apsisaugojimo priemonė.
„Stabligė iš kitų ligų išsiskiria tuo, kad žmogus nuo žmogaus neužsikrečia ir nuo šios ligos galima apsisaugoti pasiskiepijus. Tačiau valstybės lėšomis suaugusieji nuo stabligės profilaktiškai skiepijasi gana vangiai“, - sako NVSC Užkrečiamųjų ligų valdymo skyriaus vyriausioji specialistė Daiva Razmuvienė. Pernai pasiskiepijo 33 367 suaugę asmenys, užpernai - 23 277.

Didesnė rizika susirgti stablige yra asmenims, kurie niekada nebuvo skiepyti nuo šios ligos, taip pat tiems, kurie buvo skiepyti, bet negavo viso skiepų kurso ar po paskutinio skiepo praėjo daugiau nei 10 metų. Taip pat didesnė rizika susirgti šia liga yra žemės ūkyje dirbantiems asmenims, vyresnio amžiaus žmonėms, nes jų bendrasis imunitetas ir imunitetas stabligei gali būti susilpnėjęs.
Žaizdos ir pirmoji pagalba
Iškylos į gamtą ir tolimesnės kelionės neretai apkartina nedideli odos sužeidimai bei rimtesnės traumos, atsiradusios dėl neatsargaus elgesio. Bet kokia žaizda - tiek nedidelis įbrėžimas, tiek rimtesnis gilesnių audinių ar net organų pažeidimas - atveria vartus antrinei infekcijai. Susižeidus gamtoje į žaizdą gali lengvai patekti stabligės, botulizmo ir kitų pavojingų sukėlėjų.
Pirmiausia, prieš liečiantis prie bet kokios žaizdos, būtina nusiplauti rankas. Jei yra galimybė, žaizdą patariama nuplauti šiltu vandeniu ir muilu, geriausia - tekančiu. Kitu atveju tiks bet koks švarus vanduo. Po to žaizdą reikia nusausinti. Nereikėtų skubėti stabdyti kraujavimo, jeigu jis nėra pavojingas gyvybei. Toliau reikia pasirūpinti žaizdos dezinfekavimu antiseptinėmis priemonėmis, slopinančiomis mikroorganizmų dauginimąsi. Anot specialistų, puikus pasirinkimas - specialus dezinfekuojamasis purškalas, kurį patogu turėti kelionėje.
Kelionės vaistinėlėje vietą gali rasti ir kitos žaizdai praplauti ir dezinfekuoti skirtos priemonės - specialūs tirpalai, geliai, padedantys išvalyti žaizdą ir skatinantys gijimą. Naudojant šias priemones, reikėtų įvertinti žaizdą, jos gylį, paciento amžių. Dermatovenerologė primena, kad norint dezinfekuoti žaizdą galima aplink ją (bet ne pačią žaizdą) patepti trupučiu jodo, šiek tiek praskiestu su vandeniu. Toliau ant žaizdos uždėjus sterilų tvarstį reikėtų stebėti situaciją. Jeigu pasireiškia stipraus uždegimo požymiai - oda aplink žaizdą parausta, skauda, būtina kreiptis į gydytoją.
Reikia nepamiršti įvertinti ir aplinkybių, kaip buvo susižalota. Pas specialistą paskubėti reikėtų ir jei, pavyzdžiui, vaikas užlipo ant surūdijusios vinies, nes tuomet atsiranda pavojus užsikrėsti stablige. Jei nubrozdinimas yra sausas, be šlapiavimo, geriau sužeistos vietos niekuo netepti. Kraujui sukrešėjus susidaro šašas, kuris sudaro natūralią apsaugą ir sąlygas gijimui. Tuomet geriausia tiesiog uždėti sterilų tvarstį, kuris apsaugotų nuo antrinės infekcijos.
Negalima žaizdų dezinfekuoti įvairiais antiseptiniais milteliais, nenaudoti liaudiškų „dezinfekcijos“ priemonių - neberti į žaizdą miltų, druskos ir kt. Pirmąją pagalbą nelaimės vietoje teikiantis asmuo turi nuplauti žaizdą, geriau po tekančiu vandeniu. Jei tai neįmanoma, bet kokiu švariu vandeniu. Po to odą aplink žaizdą reikia apdoroti dezinfekuojančiomis antiseptinėmis priemonėmis. Jei žaizda negili, tik nubrozdinimas, antiseptinėmis priemonėmis galima tepti ir pačią žaizdą. Negalima ant žaizdos pilti įvairių spiritinių skysčių, jodo tirpalo, briliantinės žalumos, nes tiesiogiai su šiais skysčiais kontaktavę audiniai žus, ir gijimo procesas bus sudėtingesnis. Griežtai draudžiama barstyti įvairius antiseptinius miltelius. Taip pat negalima naudoti jokių liaudiškų priemonių - miltų, kiaušinio baltymo, druskos ir kt.
Pagrindiniai žingsniai suteikiant pirmąją pagalbą:
- Švariai nuplauti žaizdą.
- Odą aplink žaizdą (o jei ji negili ir pačią žaizdą) nuvalyti dezinfekuojamomis antiseptinėmis priemonėmis.
- Išrinkti tik smulkius svetimkūnius, giliai įstrigusių netraukti - kreiptis į gydymo įstaigą.
- Uždėti sterilų tvarstį.

Stabligės sukėlėjas ir simptomai
Stabligę sukelia bakterija Clostridium tetani, kuri yra labai plačiai paplitusi gamtoje, ypač dirvožemyje. Šia liga užsikrečiama stabligės bakterijoms arba sporoms patekus į žaizdą. Ypač pavojingos gilios, dirvožemiu užterštos arba purvinais įrankiais, aprūdijusiais rakandais padarytos žaizdos, tačiau stablige galima užsikrėsti ir per bet kurias kitas žaizdas: įkandus gyvūnui, stipriai nušalus, nusideginus ugnimi ar cheminėmis medžiagomis, nusiplikius verdančiais skysčiais, per pragulas.
Į žaizdą patekusios stabligės bakterijos sparčiai dauginasi ir išskiria toksinus, paveikiančius nervų sistemą. Pirmieji ligos požymiai atsiranda dažniausiai 7-14 dieną po sužeidimo. Tai gali būti trumpalaikiai raumenų trūkčiojimai užkrato patekimo vietoje. Vėliau raumenų spazmais išplinta po visą kūną, apima liemens ir galūnių raumenis, išryškėja kramtomųjų raumenų, veido, nugaros, pilvo raumenų spazmai. Šie spazmai būna labai skausmingi, jų trukmė - nuo kelių sekundžių iki kelių minučių. Ligai progresuojant jie gali būti tokie stiprūs, kad priepuolio metu gali lūžti ilgieji kaulai, dantys. Mirtis ištinka dėl asfiksijos (uždusimas), atsiradus kvėpuojamųjų raumenų spazmams. Stabligės spazmai ima stiprėti ir dažnėti, apima vis daugiau raumenų grupių. Ligoniui periodiškai susitraukia kaklo, sprando, nugaros ir liemens raumenys. Stabligė paprastai nustatoma pagal ligai būdingus, pirminius simptomus - žandikaulių ir veido spazmus. Taip pat įvertinama anamnezė, t.y. sužeidimo aplinkybės.
Švarios žaizdos perrišimas.
Svarbu kreiptis į gydytojus
Gydytojo pagalbos nereikia, jeigu žaizda yra nedidelė, paviršinė, trauma nėra kombinuota (nėra didelio sumušimo, kraujosruvos, neįtariama kaulų lūžių ar išnirimų). Visais kitais atvejais rekomenduojama atvykti į gydymo įstaigą. Gydytojas gali tinkamai įvertinti žaizdos sunkumą, įtarti infekcijų riziką, o esant reikalui, skirti skiepų nuo stabligės ar pasiutligės. Jeigu jus apkandžiojo naminis gyvūnas, būtina išsiaiškinti gyvūno savininko adresą, pavardę, telefoną, ar gyvūnas skiepytas nuo pasiutligės ir kada. Šie duomenys bus reikalingi gydytojui.
Nustačius stabligę, ligonis gydomas ligoninėje, įprastai - intensyvios terapijos skyriuje. Ligoniui sušvirkščiama serumo prieš stabligę, stabligės anatoksino arba specifinio imunoglobulino. Dėl aktyviai vykdomos prevencijos ir geros medicininės priežiūros susirgus, stabligė yra reta liga. Tačiau pavieniai atvejai vis tiek fiksuojami. Pavyzdžiui, 2017-aisiais nustatyti 3 stabligės atvejai (vienas žmogus mirė), 2016-aisiais - 2 (vienas žmogus mirė), 2015-aisiais - 2.
Visų didesnių, gilesnių ar užterštų žaizdų atveju, taip pat susižeidus ant surūdijusio metalo, būtina nedelsiant kreiptis į gydymo įstaigą. Viena moteris pasidalijo istorija, kaip jos tėtis, užlipęs ant surūdijusios vinies, patyrė stiprų skausmą ir negalėjo gauti pagalbos artimiausioje ligoninėje, kol nebuvo iškviesta greitoji medicinos pagalba ir jis nugabentas į kitą miestą. Ši situacija parodo ne tik medicininės pagalbos trūkumą kai kuriais atvejais, bet ir piliečių abejingumą bei nesupratimą, kaip elgtis kritinėse situacijose.
Sveikatos apsaugos ministerija (SAM) teigia, kad įvykus nelaimei, rekomenduojama nedelsiant kviesti greitąją medicinos pagalbą (GMP). Jei nusprendėte į ligoninę vykti savo jėgomis, turite žinoti, kad pagal galiojančią tvarką pirmąją pagalbą žmonėms užtikrina ta gydymo įstaiga, kurioje jis yra prisirašęs, o vakarais, savaitgaliais ir švenčių dienomis - kita gydymo įstaiga, su kuria yra pasirašyta sutartis dėl šių paslaugų teikimo. Svarbu žinoti, į kurią gydymo įstaigą reikėtų kreiptis dėl skubios pagalbos.
Visiems norintiems pasiskiepyti nuo stabligės rekomenduojama kreiptis į savo gydytoją.